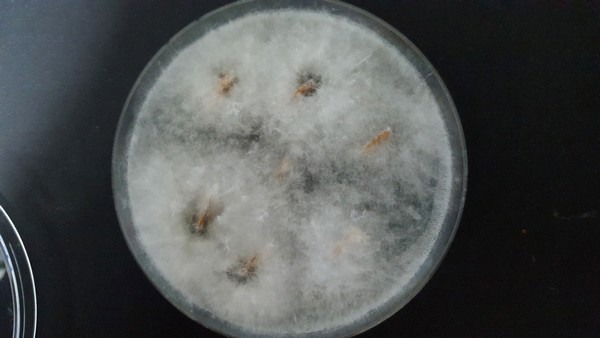

Dieback is becoming an increasingly important problem for avocado producers in Spain. This phytopathology of fungal origin, whose symptoms first become visible at the ends of the branches, with the progressive death of the tissues from the most distal to the base, has always existed and until now it was not considered greatly important, explains Eva Arrebola, researcher of the University of Malaga; but since 3-4 years ago, it has gradually been raising greater and greater concerns.

"While in the past it used to affect only a few branches, now dieback affects half of the tree and, most alarmingly, it is having an impact, to a greater or lesser extent, on the production. We are even seeing small trees fully drying out. Dieback is caused by a family of fungi called Botryosphaeriaceae, consisting of more than 25 genera that branch into about 1,500 species. All of them can cause the disease in different fruits, such as avocados, grapes or walnut, and they are airborne."
"That makes it difficult to control them, because even if one farm is making a great effort to keep the disease at bay, if the one next door or the one across the street is affected, the fungus will arrive. The diseases caused by airborne fungi can easily travel around the world, as has happened in this case." Avocado dieback is also a cause for concern in other producing areas, where its development is being closely monitored while there is hope that effective strategies will be developed in order to deal with the disease.
Neofusicoccum parvum.
Although, if this family of fungi has always existed and has been present in plantations, affecting trees to a certain extent, a question inevitably arises: why is it now more of a concern?
"The answer could lie in climate change," says Eva, "Events like drought, rain, wind... are becoming more and more extreme and weakening the trees, so those fungi that have always been there in balance because the trees could fight them are getting the chance to spread."

"In fact, some say that in the Axarquia virtually all farms are affected in some degree by this disease, especially those with young trees transplanted recently that don't yet have the strength to withstand the attack of the fungus. According to observations from the producers themselves, there may be different resistances to dieback depending on the avocado variety, with the Bacon being the one apparently showing the highest resistance. As for the Hass, the most planted variety, it has been observed to have intermediate resistance."
"In two years we will have developed a protocol that will help control it."
In the province of Malaga alone and, more specifically, in the Axarquia region, there are more than 7,000 hectares devoted to avocado production. The success of this industry, which has turned this region into the largest avocado producer in Europe, has been the result of a firm commitment on the part of agricultural producers in the region in the cultivation of this subtropical fruit, highly demanded in the international market. But it has required an equally high investment that is now threatened by the spread of the so-called dieback.

Therefore, in the framework of an agreement signed between the University of Malaga and the largest avocado cooperative in the province, TROPS, along with two of the largest nurseries in Malaga, Viveros Blanco and Viveros Brokaw, research is being carried out, seeking to establish a protocol that will allow greater control of the spread of the fungus in the fields. The goal is to give producers a solution in the shortest possible time.
"Organic farming is the future, so we are focused on finding solutions within this framework, combining strategies such as biocontrol, the use of natural compounds or field management. It is a serious problem that requires a long-term solution. We have been researching for 3 years now and we believe that in two years we will have developed a protocol that should help to control it," says Eva.
"It must be said that this year, dieback is being especially concerning due to the dry weather. High temperatures and the low water supply are causing a lot of stress on the trees, as the crop is grown fully under irrigation, and this is keeping producers stressed, as well."
For more information:
Eva Arrebola
www.mamgroup.es










